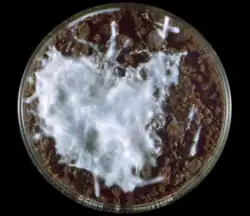

Trichophyton mentagrophytes
| Trichophyton mentagrophytes | |
|---|---|
| |
| Scientific classification | |
| Kingdom: | Fungi |
| Division: | Ascomycota |
| Class: | Eurotiomycetes |
| Order: | Onygenales |
| Family: | Arthrodermataceae |
| Genus: | Trichophyton |
| Species: | T. mentagrophytes
|
| Binomial name | |
| Trichophyton mentagrophytes (Robin) Blanchard (1853)
| |
Trichophyton mentagrophytes is a species in the fungal genus Trichophyton.[1] It is one of three common fungi which cause ringworm in companion animals. It is also the second-most commonly isolated fungus causing tinea infections in humans, and the most common or one of the most common fungi that cause zoonotic skin disease. Trichophyton mentagrophytes is frequently isolated from dogs, cats, rabbits, guinea pigs and other rodents,[2][3][4] though at least some genetic variants possess the potential of human-to-human transmission, e.g. Type VII[5] and Type VIII.[6] As of 2024 it is an emerging STD in men who have sex with men and in sex workers of all genders.
Nomenclature
Along with closely related T. interdigitale, the species has been traditionally treated as a part of polyphyletic assemblage, named "T. mentagrophytes sensu lato".[7][8] From 1999 to 2017 the two species have been collectively referred to as T. interdigitale, while the name "T. mentagrophytes" has been used for current T. quinckeanum.[1][9][10] Trichophyton interdigitale seems to be strictly anthropophilic,[11][8] and is associated with foot and nail infections.[12]
Mating and meiosis
Trichophyton mentagrophytes is capable of mating.[13] This species is also able to undergo meiosis.[14] The haploid chromosome complement of T. mentagrophytes is four. The fusion of haploid nuclei (karyogamy) preceding meiosis occurs in the penultimate cell of a typical crozier, an anatomical feature of the sexual phase of many fungi in the Division Ascomycota.
Effect in mammals
Trichophyton mentagrophytes is one of three common fungi which cause ringworm in companion animals and frequently isolated from dogs, cats, rabbits, guinea pigs and other rodents.[2][3][4]
It is the most common or one of the most common fungi that cause zoonotic skin disease (i.e., transmission of mycotic skin disease from species to species).[2][3][4]
While it is considered a zoophilic species, it is also the second-most commonly isolated fungus causing tinea infections in humans, and at least some genetic variants possess the potential of human-to-human transmission, e.g. Type VII[5] and Type VIII.[6]
Since 2002 cases were reported in Nigerian sex workers, in 2021 in men who have sex with men in France and as of 2024 in New York City.[15]
Epidemiology
Particular genetic variants of the fungus have distinct geographic ranges.[12]
For studies on the epidemiology of T. mentagrophytes, two molecular strain typing techniques are available. The first one is based upon amplification of nontranscribed spacer of ribosomal DNA,[16] and the second one involves a comparison of internal transcribed spacer sequences within defined boundaries.[12]
Treatment and drug resistance
In T. mentagrophytes, antifungal drug resistance is mainly associated with Type VIII isolates. Drug-resistant T. mentagrophytes strains have been found in many places across Asia and Europe. India is the most affected country, with the rate of microbiological resistance to terbinafine estimated at 11.4%.[17] There are also reports on terbinafine-resistant Type II isolates from Japan and Denmark.
References
- ^ a b de Hoog GS, Dukik K, Monod M, et al. (2017). "Toward a novel multilocus phylogenetic taxonomy for the dermatophytes". Mycopathologia. 182 (1–2): 5–31. doi:10.1007/s11046-016-0073-9. PMC 5283515. PMID 27783317.
- ^ a b c Cafarchia C, Weigl S, Figueredo LA, Otranto D (2012). "Molecular identification and phylogenesis of dermatophytes isolated from rabbit farms and rabbit farm workers". Veterinary Microbiology. 154 (3–4): 395–402. doi:10.1016/j.vetmic.2011.07.021. PMID 21840652.
- ^ a b c Mesquita JR, Vasconcelos-Nóbrega C, Oliveira J, et al. (2016). "Epizootic and epidemic dermatophytose outbreaks caused by Trichophyton mentagrophytes from rabbits in Portugal, 2015". Mycoses. 59 (10): 668–673. doi:10.1111/myc.12513. hdl:10400.19/3518. PMID 27292309. S2CID 206200544.
- ^ a b c Bartosch T, Frank A, Günther C, et al. (2018). "Trichophyton benhamiae and T. mentagrophytes target guinea pigs in a mixed small animal stock". Medical Mycology Case Reports. 23: 37–42. doi:10.1016/j.mmcr.2018.11.005. PMC 6290094. PMID 30560049.
- ^ a b Gallo JG, Woods M, Graham RM, Jennison AV (2017). "A severe transmissible Majocchi's granuloma in an immunocompetent returned traveler". Medical Mycology Case Reports. 18: 5–7. doi:10.1016/j.mmcr.2017.07.003. PMC 5502794. PMID 28725545.
- ^ a b Larionov MD, Chilina GA, Bogdanova TV, Pchelin IM (2017). "Rare clinical case of tinea corporis and tinea cruris due to Trichophyton mentagrophytes of exotic genotype". Problemy Medicinskoj Mikologii. 19 (2): 95.
- ^ Nenoff P, Herrmann J, Gräser Y (2007). "Trichophyton mentagrophytes sive interdigitale? A dermatophyte in the course of time". Journal der Deutschen Dermatologischen Gesellschaft. 5 (3): 198–202. doi:10.1111/j.1610-0387.2007.06180.x. PMID 17338794. S2CID 24939746.
- ^ a b Heidemann S, Monod M, Gräser Y (2010). "Signature polymorphisms in the internal transcribed spacer region relevant for the differentiation of zoophilic and anthropophilic strains of Trichophyton interdigitale and other species of T. mentagrophytes sensu lato". British Journal of Dermatology. 162 (2): 282–295. doi:10.1111/j.1365-2133.2009.09494.x. PMID 19886885. S2CID 31375222.
- ^ Gräser Y, Kuijpers AF, Presber W, de Hoog GS (1999). "Molecular taxonomy of Trichophyton mentagrophytes and T. tonsurans". Medical Mycology. 37 (5): 315–330. doi:10.1046/j.1365-280x.1999.00234.x. PMID 10520156.
- ^ Beguin H, Pyck N, Hendrickx M, Planard C, Stubbe D, Detandt M (2012). "The taxonomic status of Trichophyton quinckeanum and T. interdigitale revisited: a multigene phylogenetic approach". Medical Mycology. 50 (8): 871–882. doi:10.3109/13693786.2012.684153. PMID 22587727.
- ^ Pchelin IM, Azarov DV, Churina MA, et al. (2019). "Species boundaries in the Trichophyton mentagrophytes / T. interdigitale species complex". Medical Mycology. 57 (6): 781–789. doi:10.1093/mmy/myy115. PMID 30462248. Retrieved 2020-01-24.
- ^ a b c Taghipour S, Pchelin IM, Zarei Mahmoudabadi A, et al. (2019). "Trichophyton mentagrophytes and T interdigitale genotypes are associated with particular geographic areas and clinical manifestations". Mycoses. 62 (11): 1084–91. doi:10.1111/myc.12993. PMID 31444823. S2CID 201631215.
- ^ Kawasaki, M.; Anzawa, K.; Wakasa, A.; Takeda, K.; Mochizuki, T.; Ishizaki, H.; Hemashettar, B. (2010). "Matings among three teleomorphs of Trichophyton mentagrophytes". Nihon Ishinkin Gakkai Zasshi = Japanese Journal of Medical Mycology. 51 (3): 143–152. doi:10.3314/jjmm.51.143. PMID 20716853.
- ^ Weitzman, I.; Allderdice, P. W.; Silva-Hutner, M.; Miller, O. J. (1968). "Meiosis in Arthroderma benhamiae (=Trichophyton mentagrophytes)". Sabouraudia. 6 (3): 232–237. doi:10.1080/00362176885190441. PMID 5679669.
- ^ Zucker, Jason (2024). "Notes from the Field: Trichophyton mentagrophytes Genotype VII — New York City, April–July 2024". MMWR. Morbidity and Mortality Weekly Report. 73 (43): 985–988. doi:10.15585/mmwr.mm7343a5. ISSN 0149-2195. PMC 11527365. PMID 39480750.
- ^ Jackson CJ, Mochizuki T, Barton RC (2006). "PCR fingerprinting of Trichophyton mentagrophytes var. interdigitale using polymorphic subrepeat loci in the rDNA nontranscribed spacer". Journal of Medical Microbiology. 55 (Pt 10): 1349–1355. doi:10.1099/jmm.0.46691-0. PMID 17005783.
- ^ Shaw D, Singh S, Dogra S, et al. (2020). "MIC and upper limit of wild-type distribution for 13 antifungal agents against a Trichophyton mentagrophytes-Trichophyton interdigitale complex of Indian origin". Antimicrobial Agents and Chemotherapy. 64 (4): e01964-19. doi:10.1128/AAC.01964-19. PMC 7179294. PMID 32015042.